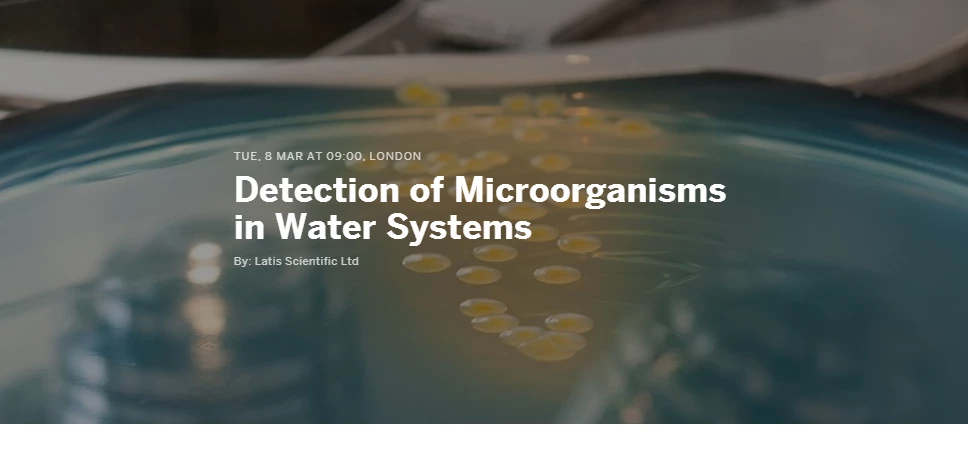
Detection of Microorganisms in Water Systems

Partner Article
Conference: Detection of Microorganisms in Water Systems
Latis Scientific are pleased to announce their 2016 conference on Detection of Microorganisms in Water Systems.
The event is free to attend, and you will have the opportunity to hear industry experts discuss the latest research and developments in methodologies used. Speakers include Dr. Hans-Anton Keserue of the Swiss Federal Institute of Aquatic Research (Eawag) and Dr Samuel Collins from Public Health England.
The programme includes a range of topics including:
- Detection of Legionella bacteria using rapid technologies such as qPCR; including the latest technology for differentiating between live and dead cells.
- The use and immunological methods for the onsite testing for Legionella.
- Emerging technologies in the water field, such as flow cytometry and real time sensors.
- A new validated qPCR method for the detection of Mycobacteria; an opportunistic pathogen causing increasing issue within the healthcare sector.
- A novel green technology for the removal of biofilm with potential to significantly change current disinfection regimes.
Business Development Director at Latis Scientific, Ian Mein said:
“Our first sponsored event is designed to look at new technologies that are pertinent to the built environment and provide an open forum into future practises for the industry.“
The conference will take place on the 8th March at the Royal College of Physicians in London. For further details and to register for free click here.
About Latis Scientific
Latis Scientific is a market leading provider of laboratory services. For more please visit http://www.latisscientific.co.uk
This was posted in Bdaily's Members' News section by Katherine MacBeth .
Enjoy the read? Get Bdaily delivered.
Sign up to receive our popular morning National email for free.